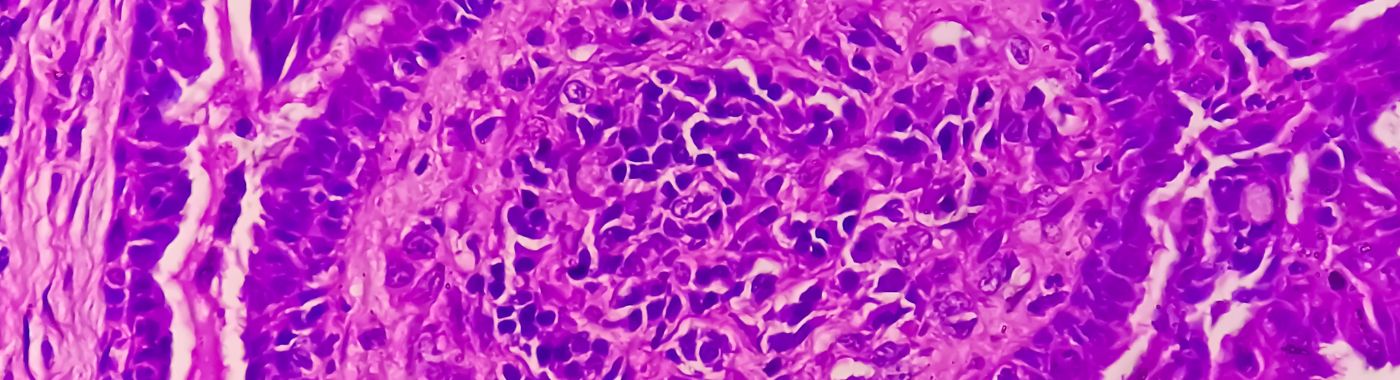
Atypical Endometrial Hyperplasia - Causes, Symptoms, Diagnosis, Treatment, and Prevention
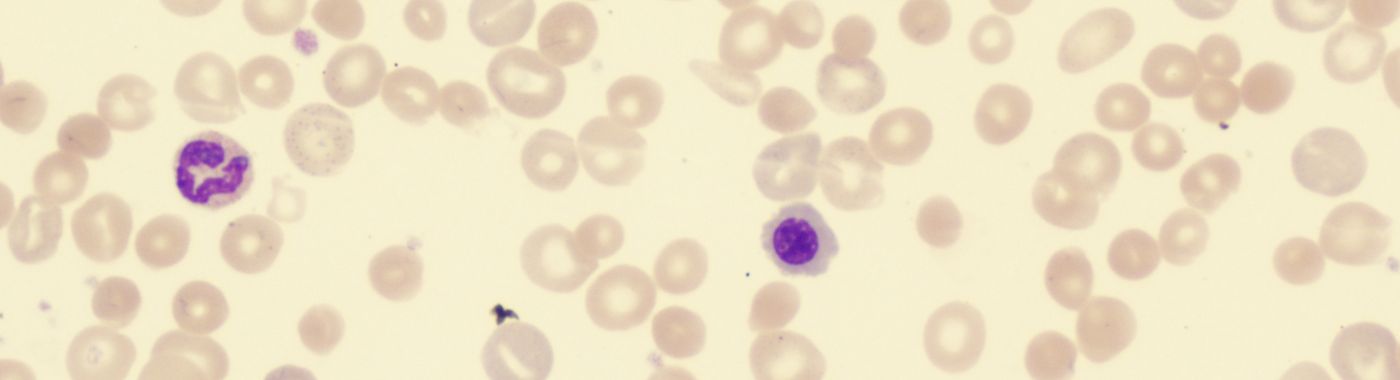
Autoimmune Hemolytic Anemia - Causes, Symptoms, Diagnosis, Treatment, and Prevention

Disease and condition
Detailed Insights into Causes, Risk Factors, Prevention, and Management
Disease and condition (2352)
Read More


Attention Deficit Hyperactivity Disorder (ADHD) - Causes, Symptoms, Diagnosis, Treatment and Prevention
Read More


Atypical Hemolytic Uremic Syndrome - Causes, Symptoms, Diagnosis, Treatment, and Prevention

Best Hospital Near me Chennai
Best Hospital Near me Chennai

